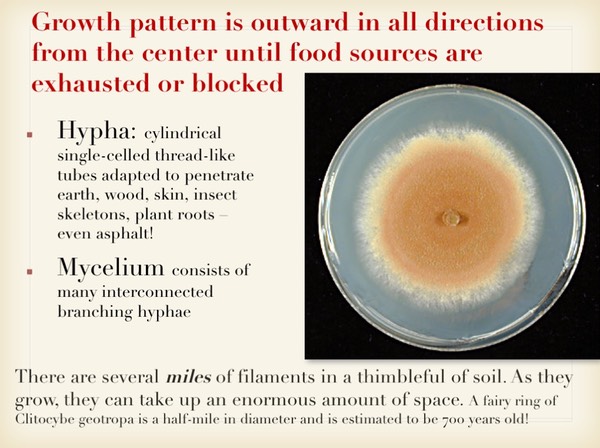
Slide010

This presentation is the most recent (2017) and thorough iteration of many talks I have given on this subject to mycology clubs, education centers, universities and nature venues. The thrust of the program is to give everyone a better foundation for understanding the planet’s long history of cooperation with members of this kingdom over many hundreds of millions of years, our historical and contemporary dependence on them, and their potential uses for solving some of our most challenging environmental and health problems. I hope to relieve you of fears and misunderstandings you may have about wild mushrooms and help you appreciate their many functions, their potential to heal, and the beauty of these ephemeral wonders of existence.
Kindly click on PDF to view the entire program in full screen mode. You can also view each slide and progress through them all to the end. Last updated 3/9/17.